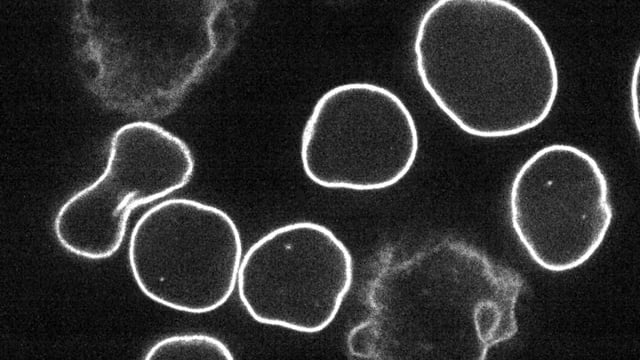
Video thumbnail
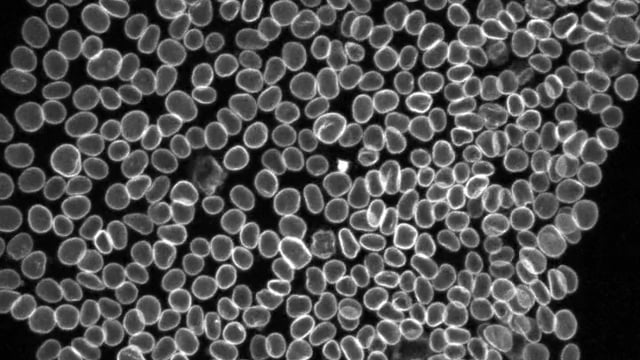
Video thumbnail

NCBI Isoforms:NM_005573 |
crRNA Target Site:GGGGTCGCAGTCGCCATGGC |
Linker: SGLRSRAQAS |
Cas9:Wildtype spCas9 |
AICS-0013
LMNB1 in WTC-mEGFP (mono-allelic tag)
Single image of a live hiPSC colony expressing LaminB1-mEGFP. Image is a maximum intensity projection of a spinning-disk confocal z-stack.

EditingDesign
GenomicCharacterization
StemCellCharacteristics
mEGFP Insert

